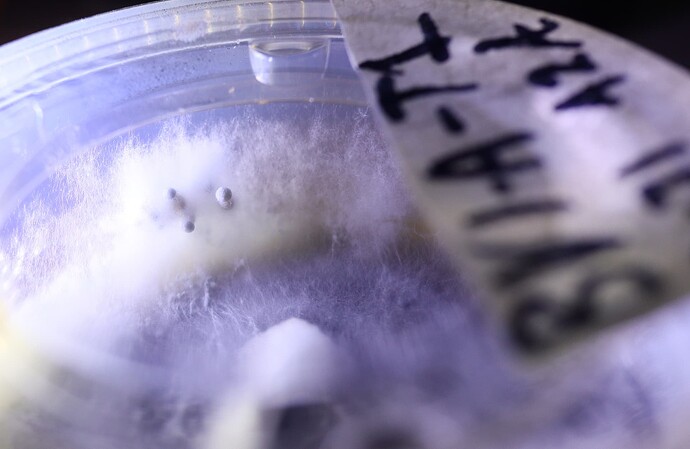

Stir fry or cream of mushroom soup are my go to for oysters
OMNI
Yes that cluster on the scale weighs 594g!
These blob fruits are insane, coral reef crossed with blue cauliflower
For one fruit that’s a beast! I get a lot of 100-200 on a few varieties, but my OMNI was a big cluster that had to be broken apart. I’ll have a dry weight in a day or two
Makilla Gorilla has a pretty gill structure (pictured above)
Inverts are pretty neat too
Most strains will do it if u leave them in the bag/tub long enough but not all of them are pretty. Most look gnarly and once dried dont look great either, finding an invert strain that still looks great after drying has been quite the challenge
I thought 1oz dry was crazy
Great job. What sub?
Tbh ive just been throwing shit together and it works most of the time.
Current recipe is coco, verm, horse manure, Dry Nutrient Powder mix, and agtonik.
No casing layer.
Sub is mixed at a ratio of 2:1 (sub:grain) into 5lb final bags.
Usually takes 2 weeks to fully inocluate, 3 weeks to start seeing pinning and youll be picking 3-4 oz (dry weight) worth in a month from innoculation.
Heaviest yield from a 5lb bag has been DC Mak, at about 12oz per bag after 3 flushes. Total of 2 months in the bag from spawn to finish.
That’s really great for a 5# bag
My data on the monotubs with 4# grain, 10# sub was about 12 average dry after 3 flushes. Some were 6, some 18. Strain was really important as well as culture health. Hillybilly and Thrasher being my top 2
That isnt near my average yield though that was an outlier, maybe that particular horse was heady and was eating all the exotic flowers and grasses while the rest ate the midz grass
Damn thats top tier potency, over 1% (psilocibin + psilocin) are some great results. What subtrate was this grown on?
Grain and buffered coir uncased. It’s really just a great variety.
It was a culture yesterday, now it’s both a culture and fruit pic. Pan cyan BVI culture on AC/MEA agar, showing pins 10 days after first transfer from MS germ plate.